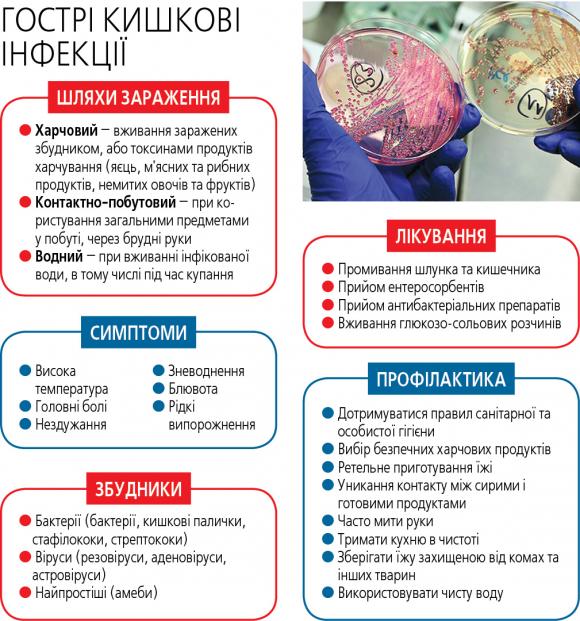
Профілактика гострих кишкових інфекцій
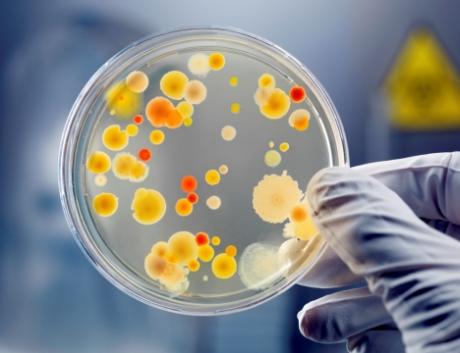
Профілактика гострих кишкових інфекцій

Пік кишкових інфекцій зазвичай припадає на спекотну пору року. Підвищена температура навколишнього середовища сприяє поширенню збудників, які викликають захворювання на кишкові інфекції. До організму такі збудники потрапляють, головним чином, з інфікованою водою, зіпсованими та неякісними харчовими продуктами або контактно-побутовим шляхом через брудні руки.
Основною причиною виникнення гострих кишкових інфекцій є елементарне недотримання правил особистої гігієни, технології приготування страв, умов та термінів зберігання сировини та готових страв, вживання неякісних харчових продуктів, які містять в собі збудник захворювання тощо.
Для профілактики гострих кишкових інфекцій необхідно:
- дотримуватися правил особистої гігієни;
- ретельно мити руки з милом перед вживанням їжі, після повернення з вулиці та після кожного відвідування вбиральні;
- мити та тримати у чистоті всі поверхні та кухонні прилади, що використовуються для приготування їжі;
– користуватися індивідуальним посудом; - запобігати проникненню комах та тварин до приміщень, де відбувається приготування їжі та зберігаються харчові продукти;
- регулярно мити та обдавати окропом дитячий посуд та іграшки;
- окремо готувати і зберігати сирі та готові до вживання харчові продукти (сире м’ясо, птицю, рибу, овочі, фрукти тощо);
- для обробки сирих продуктів використовувати окремі кухонні прилади (ножі, обробні дошки тощо);
- добре просмажувати чи проварювати продукти, особливо м’ясо, птицю, яйця і рибу;
- дотримуватися відповідного температурного режиму при зберіганні харчових продуктів (не залишати приготовлені харчові продукти при кімнатній температурі більше, ніж на 2 години);
- використовувати безпечну воду, не пити воду з неперевірених джерел;
- вживати бутильовану воду, у разі неможливості придбання такої води використовувати охолоджену кип’ячену воду;
- використовувати харчові продукти, оброблені з метою підвищення їх безпеки, наприклад, пастеризоване молоко;
- мити та обдавати окропом фрукти і овочі, особливо у разі споживання їх у сирому вигляді;
- не вживати продукти з вичерпаним терміном придатності, використовувати для приготування їжі тільки свіжі харчові продукти;
- при транспортуванні і зберіганні харчових продуктів використовувати чисту упаковку (поліетилен, контейнери для харчових продуктів тощо);
- не купувати харчові продукти у випадкових осіб або у місцях несанкціонованої торгівлі;
- не давати маленьким дітям некип’ячене розливне молоко, сирі яйця тощо;
- не купатися у непроточних водоймах, у місцях несанкціонованих пляжів, уникати заковтування води під час купання;
- уникати контактів з особами, які мають ознаки інфекційного захворювання;
- при появі симптомів захворювання (підвищення температури тіла, головний біль, інтоксикація, блювота, рідкі випорожнення, біль у животі, висипання на шкірі тощо) своєчасно звертатися за медичною допомогою.